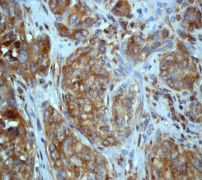

> Antigen, Antibodies, ELISA, Western Blot > Primary Antibody > Monoclonal Antibodies > JNK2 AntibodyBrand |
Leading Biology | Catalog Number |
APR08056G |
Product Type |
Monoclonal Antibodies | Field of Research |
|
Product Overview |
We constantly strive to ensure we provide our customers with the best antibodies. As a result of this work we offer this antibody in purified format.
We are in the process of updating our datasheets. If you have any questions regarding this update, please feel free to contact our technical support team.
This product is a high quality JNK2 antibody.
|
||
Molecular Weight |
48139 Da
|
||
Cellular Localization |
Antigen Cellular Localization:
Cytoplasm. Nucleus
|
||
Host |
Rabbit
|
||
Species Reactivity |
Human, Mouse, Rat
|
||
Target |
A synthetic peptide corresponding to residues near the C-terminus of human JNK2 was used as an immunogen.
|
||
Clone |
EP1595Y
|
||
Symbol |
JNK2, PRKM9, SAPK1A
|
||
GeneID |
|||
UniProt ID |
|||
Function |
Serine/threonine-protein kinase involved in various processes such as cell proliferation, differentiation, migration, transformation and programmed cell death. Extracellular stimuli such as proinflammatory cytokines or physical stress stimulate the stress-activated protein kinase/c-Jun N-terminal kinase (SAP/JNK) signaling pathway. In this cascade, two dual specificity kinases MAP2K4/MKK4 and MAP2K7/MKK7 phosphorylate and activate MAPK9/JNK2. In turn, MAPK9/JNK2 phosphorylates a number of transcription factors, primarily components of AP-1 such as JUN and ATF2 and thus regulates AP-1 transcriptional activity. In response to oxidative or ribotoxic stresses, inhibits rRNA synthesis by phosphorylating and inactivating the RNA polymerase 1-specific transcription initiation factor RRN3. Promotes stressed cell apoptosis by phosphorylating key regulatory factors including TP53 and YAP1. In T-cells, MAPK8 and MAPK9 are required for polarized differentiation of T-helper cells into Th1 cells. Upon T-cell receptor (TCR) stimulation, is activated by CARMA1, BCL10, MAP2K7 and MAP3K7/TAK1 to regulate JUN protein levels. Plays an important role in the osmotic stress-induced epithelial tight-junctions disruption. When activated, promotes beta-catenin/CTNNB1 degradation and inhibits the canonical Wnt signaling pathway. Participates also in neurite growth in spiral ganglion neurons. Phosphorylates the CLOCK-ARNTL/BMAL1 heterodimer and plays a role in the regulation of the circadian clock (PubMed:22441692).
|
||
Summary |
JNK protein kinases are distantly related to mitogen-activated protein kinases (ERKs) and are activated by dual phosphorylation on Tyr and Thr. The JNK protein kinase group includes the 46-kDa isoform JNK1 and the 55-kDa protein kinase JNK2. The activities of both JNK isoforms are markedly increased by exposure of cells to UV radiation (1). JNK becomes activated in vivo in response to pro-inflammatory cytokines or cellular stresses. Its full activation requires the phosphorylation of a threonine and a tyrosine residue in a Thr-Pro-Tyr motif, which can be catalysed by the protein kinases mitogen-activated protein kinase kinase MKK4 and MKK7 (2). JNK2 functions in a cell-type-specific and stimulus-dependent manner, being required for apoptosis of immature thymocytes induced by anti-CD3 antibody but not for apoptosis induced by anti-Fas antibody, UVC or dexamethasone. JNK2 is not required for activation-induced cell death of mature T cells (3).
|
||
Form |
50 mM Tris-Glycine (pH 7.4), 0.15 M NaCl, 40% Glycerol, 0.01% sodium azide and 0.05% BSA. |
||
Storage & Stability |
Store at +4°C short term. For long-term storage, aliquot and store at -20°C or below. Stable for 12 months at -20°C. Avoid repeated freeze-thaw cycles.
|
||
Applications |
WB, IHC
|
||
Dilution |
WB~~1:500
IHC~~1:100~250
|
||
Synonyms |
Mitogen-activated protein kinase 9, MAP kinase 9, MAPK 9, JNK-55, Stress-activated protein kinase 1a, SAPK1a, Stress-activated protein kinase JNK2, c-Jun N-terminal kinase 2, MAPK9, JNK2, PRKM9, SAPK1A
|
||
Images |

A. Western blot analysis on HeLa cell lysate using anti-JNK2 RabMAb (Cat. APR08056G), dilution 1:50,000.
B. Immunohistochemical staining of paraffin-embedded human breast carcinoma using anti-JNK2 RabMAb (Cat. APR08056G). |
||
Specification |
|||
Quantity |
|
||
| Select | Brand | Catalog No. | Product Name | Pack Size | Type | Field of Research | Specification | Quantity | Price(USD) | |
| 1 | Leading Biology | APG02467G | CCK4 / PTK7 Antibody (clone 4F9) | 50 μl | Monoclonal Antibodies |
|
$495.00 | Add Ask | ||
| 2 | Leading Biology | AMM04683G | GALT Antibody (clone 4C11) | 50 μg | Monoclonal Antibodies |
|
$545.00 | Add Ask | ||
| 3 | Leading Biology | AMM01402G | Vimentin (Mesenchymal Cell Marker) Antibody - With BSA and Azide | 50 ug | Monoclonal Antibodies |
|
$395.00 | Add Ask | ||
| 4 | Leading Biology | APR08280G | LTA4H / LTA4 Antibody (clone 9G8) | 50 μl | Monoclonal Antibodies |
|
$495.00 | Add Ask | ||
| 5 | Leading Biology | AMM00172G | CD1a / HTA1 (Mature Langerhans Cells Marker) Antibody - With BSA and Azide | 50 ug | Monoclonal Antibodies |
|
$395.00 | Add Ask | ||
| 6 | Leading Biology | AMM05750G | CEBPA Antibody | 100 μl | Monoclonal Antibodies |
|
$545.00 | Add Ask |
 Leading Biology Inc.
2600 Hilltop DR, Building G, B Suite C138
Richmond, CA, 94806
Tel: 1-661-524(LBI)-0262
Email: info@leadingbiology.com
Leading Biology Inc.
2600 Hilltop DR, Building G, B Suite C138
Richmond, CA, 94806
Tel: 1-661-524(LBI)-0262
Email: info@leadingbiology.com
Complete this form and click send to ask us a question, request a quote or simply say hello.

You have 0 item in your cart

You have 0 item in your inquiry list
